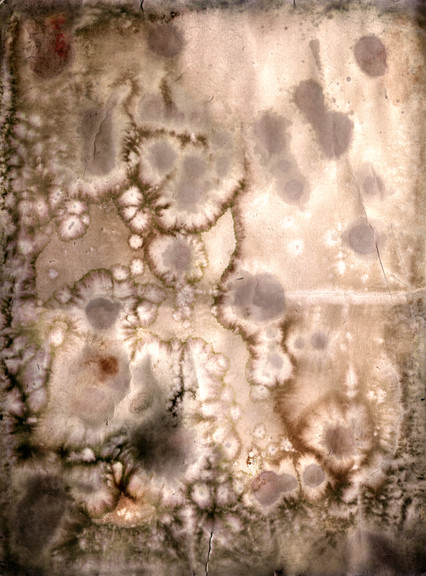

HOME | DD
 zombiecore — ftw
zombiecore — ftw

Published: 2010-01-15 07:31:43 +0000 UTC; Views: 864; Favourites: 2; Downloads: 0
Redirect to original
Description
been feeling pretty shitty lately so i thought painting might take my mind of things. i havent painted for myself in probably 4 years. it really is therapeutic so i think i might start doing it more.(2 separate paintings)
materials: liquid latex, gouache paint, fabric paint, cigarette ashes. toilet paper, notebook paper